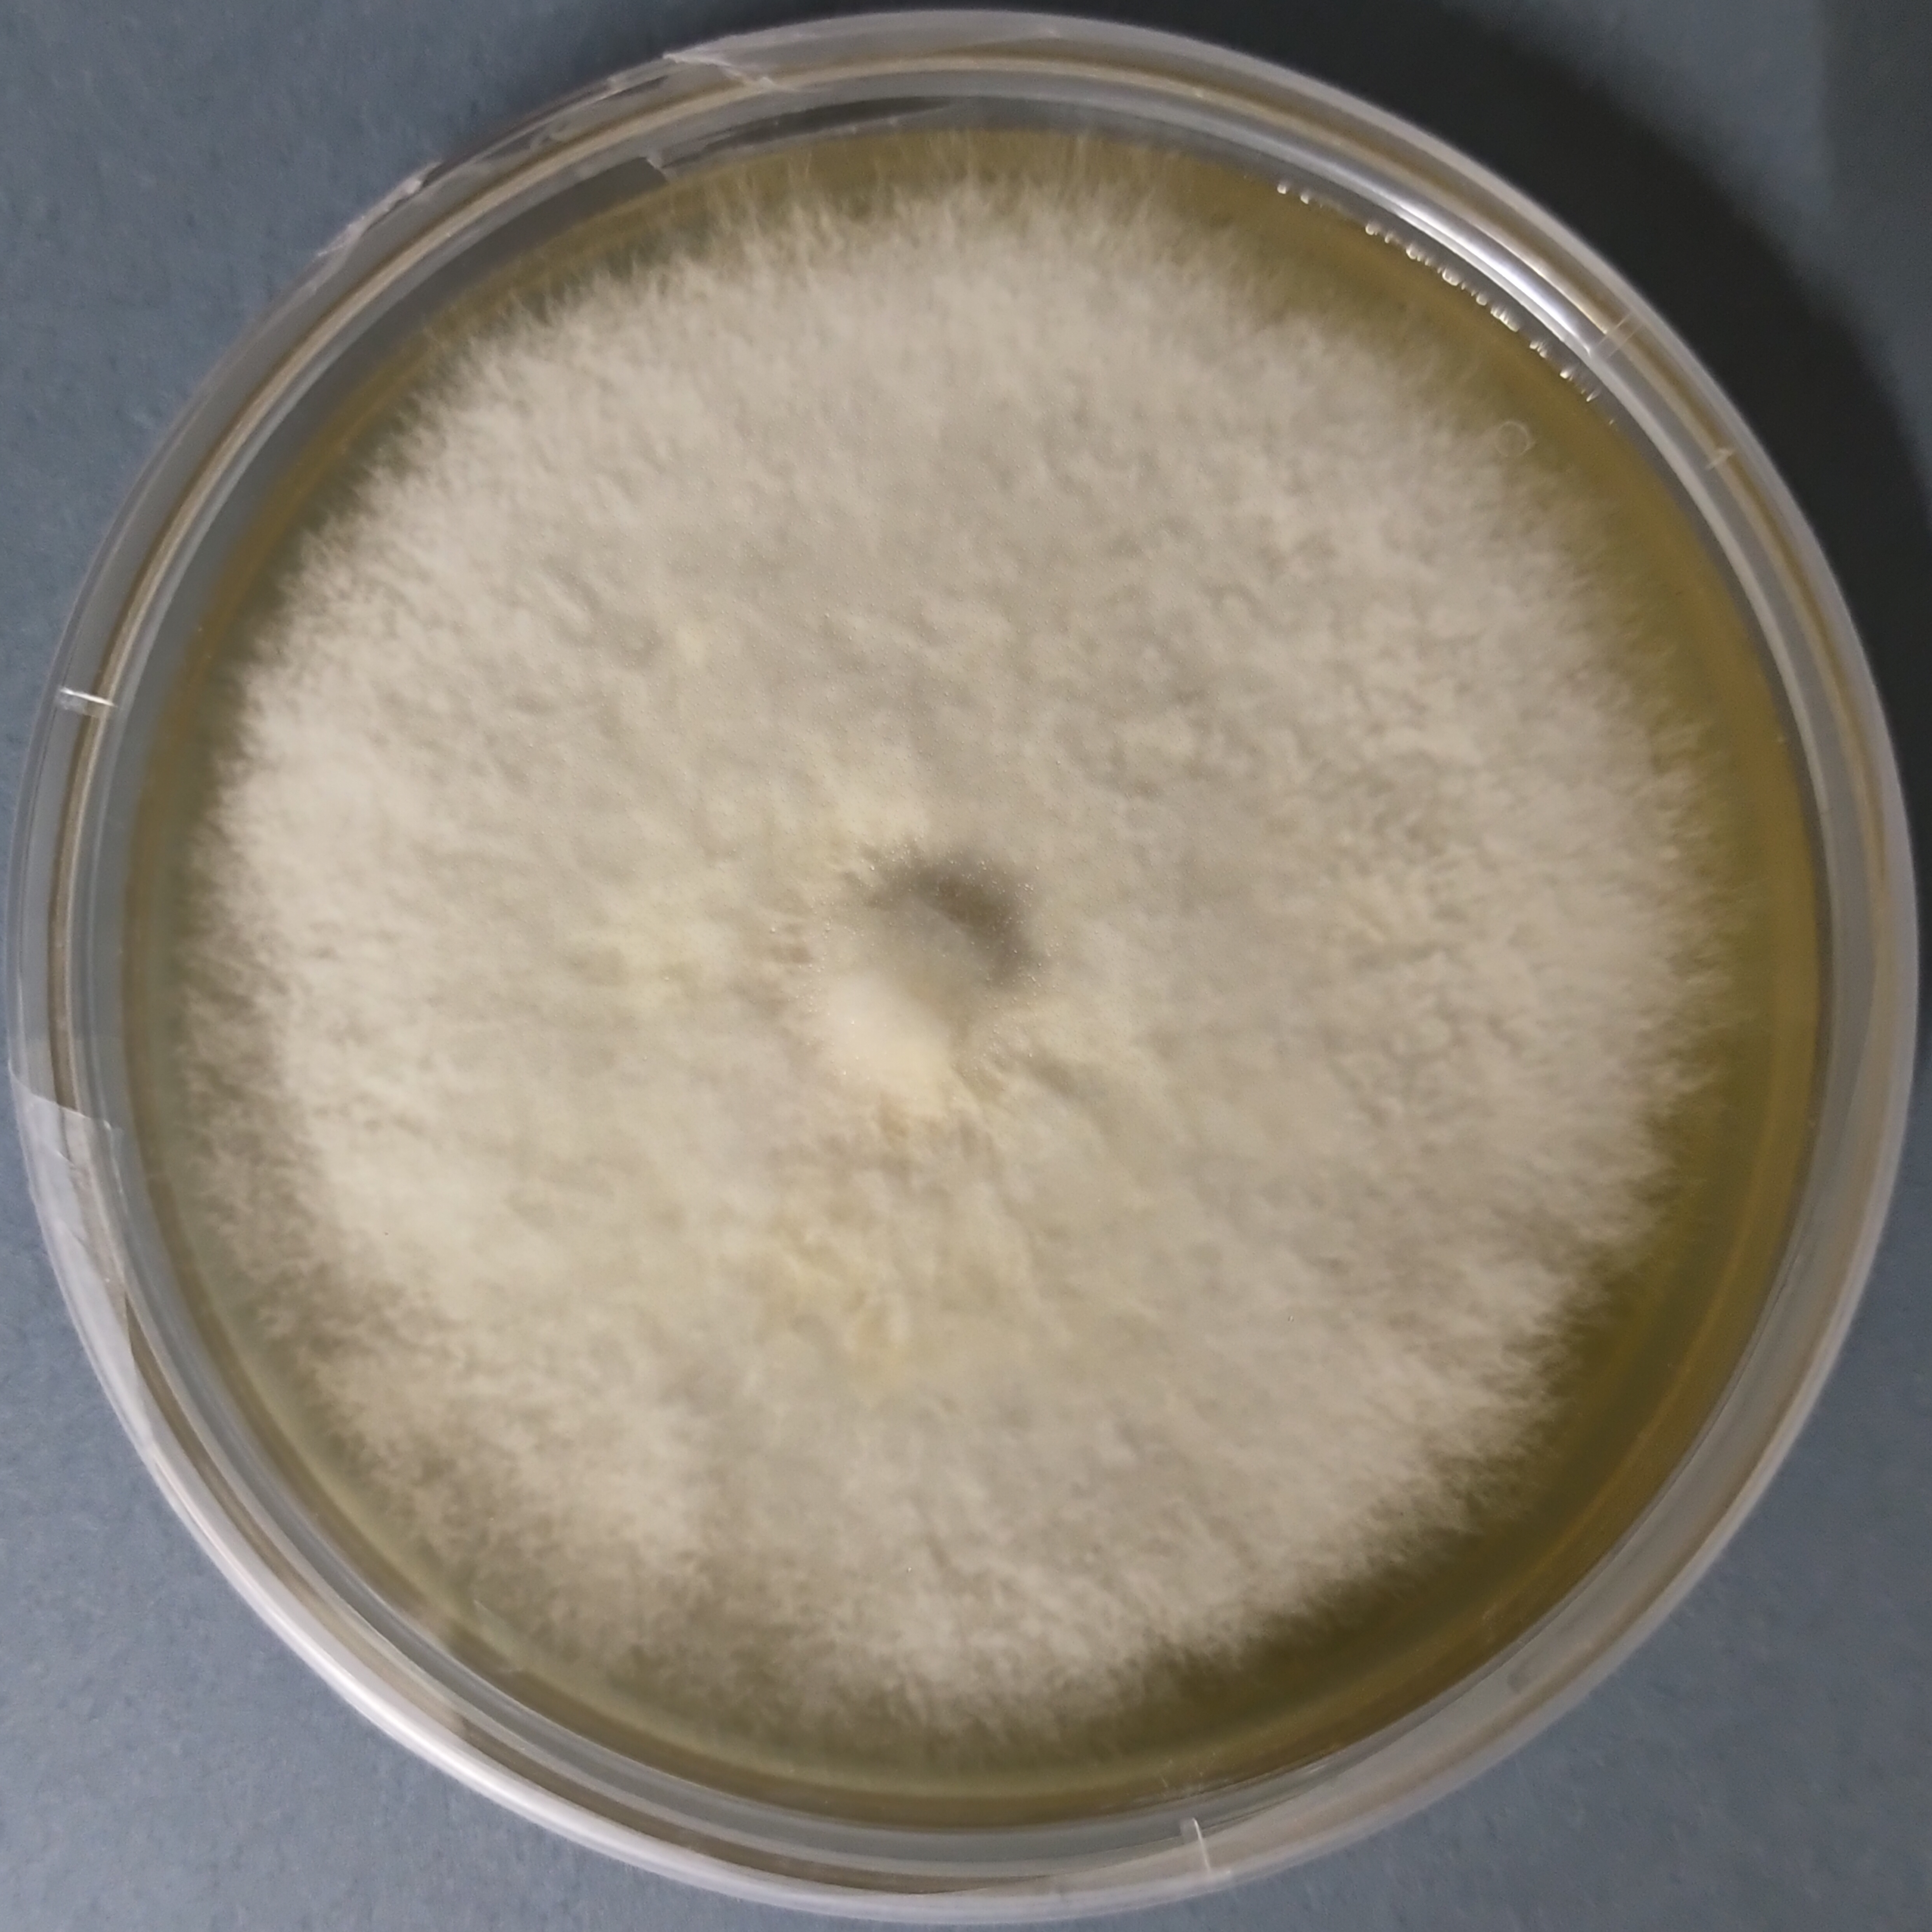
Pholiota adiposa Pure Culture (Chestnut Mushroom)

Lentinula edodes Shiitake mushroom Culture Warm Weather
₹2,500.00
You’re now subscribed to price tracking for this product. We’ll notify you if the price drops.
Unlock the gourmet delight of fresh Shiitake mushrooms with Agripie’s Lentinula edodes (Shiitake) Warm Weather Pure Culture Plate. Specially adapted for tropical and subtropical climates, this premium pure culture is ideal for growers in India looking to achieve reliable yields even in warmer temperatures. Shiitake mushrooms are highly prized for their robust umami flavor, nutritional richness, and medicinal benefits, making them a popular choice for culinary enthusiasts and commercial cultivators alike.
Agripie’s pure culture plates are meticulously developed and maintained in sterile laboratory conditions, ensuring robust, vigorous, and contamination-free growth. Perfect for cultivation in wood logs, sawdust blocks, or various agricultural wastes.
Product Features
✅ Pure Lentinula edodes mycelium culture
✅ Specifically adapted for warm weather cultivation
✅ Robust and vigorous mycelial growth
✅ Laboratory-produced under strict sterile conditions
✅ Ideal for spawn production, research, and commercial cultivation
✅ Compatible with logs, sawdust substrates, and agro-wastes
✅ Proudly produced in 🇮🇳 India by Agripie
| Weight | 0.1 g |
|---|
Only logged in customers who have purchased this product may leave a review.

Reviews
There are no reviews yet.